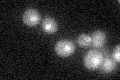
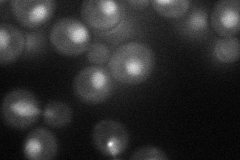
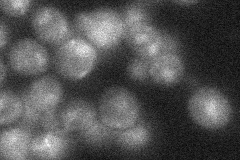
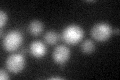
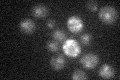

View description
Histone acetyltransferase catalytic subunit of NuA3 complex that acetylates histone H3, involved in transcriptional silencing; homolog of the mammalian MOZ proto-oncogene; sas3 gcn5 double mutation confers lethality
Localization:
Intensity:
Fold change:
Significance:
-
C’ GFP library in SD
nucleus18.04 -
N' NOP1pr-GFP in SD
punctate,nucleus40.9874 -
N' TEF2pr-mCherry in SD

nucleus18.6497 -
N' NATIVEpr-GFP in SD
punctate,nucleus21.4347 -
N' TEF2pr-VC and Cyto-VN in SD

below threshold27.6655 -
C’ GFP library in SD+DTT
nucleus19.41.07No -
C’ GFP library in SD+H2O2

nucleus16.760.92No -
C’ GFP library in Starvation Media
nucleus18.281.01No -
C’ GFP library on the background of Pup2-DaMP

nucleus -
C’ GFP library on the background of CCT mutant

nucleus16.89620.936389No
